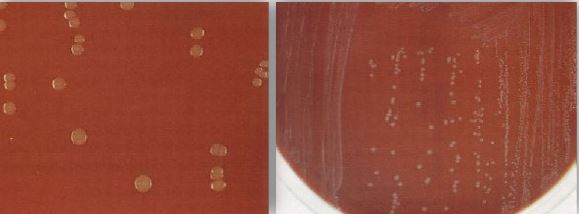
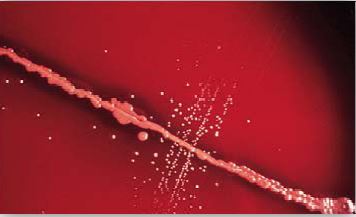

النبات

مواضيع عامة في علم النبات

الجذور - السيقان - الأوراق

النباتات الوعائية واللاوعائية

البذور (مغطاة البذور - عاريات البذور)

الطحالب

النباتات الطبية


الحيوان

مواضيع عامة في علم الحيوان

علم التشريح

التنوع الإحيائي

البايلوجيا الخلوية


الأحياء المجهرية

البكتيريا

الفطريات

الطفيليات

الفايروسات


علم الأمراض

الاورام

الامراض الوراثية

الامراض المناعية

الامراض المدارية

اضطرابات الدورة الدموية

مواضيع عامة في علم الامراض

الحشرات


التقانة الإحيائية

مواضيع عامة في التقانة الإحيائية


التقنية الحيوية المكروبية

التقنية الحيوية والميكروبات

الفعاليات الحيوية

وراثة الاحياء المجهرية

تصنيف الاحياء المجهرية

الاحياء المجهرية في الطبيعة

أيض الاجهاد

التقنية الحيوية والبيئة

التقنية الحيوية والطب

التقنية الحيوية والزراعة

التقنية الحيوية والصناعة

التقنية الحيوية والطاقة

البحار والطحالب الصغيرة

عزل البروتين

هندسة الجينات


التقنية الحياتية النانوية

مفاهيم التقنية الحيوية النانوية

التراكيب النانوية والمجاهر المستخدمة في رؤيتها

تصنيع وتخليق المواد النانوية

تطبيقات التقنية النانوية والحيوية النانوية

الرقائق والمتحسسات الحيوية

المصفوفات المجهرية وحاسوب الدنا

اللقاحات

البيئة والتلوث


علم الأجنة

اعضاء التكاثر وتشكل الاعراس

الاخصاب

التشطر

العصيبة وتشكل الجسيدات

تشكل اللواحق الجنينية

تكون المعيدة وظهور الطبقات الجنينية

مقدمة لعلم الاجنة


الأحياء الجزيئي

مواضيع عامة في الاحياء الجزيئي


علم وظائف الأعضاء


الغدد

مواضيع عامة في الغدد

الغدد الصم و هرموناتها

الجسم تحت السريري

الغدة النخامية

الغدة الكظرية

الغدة التناسلية

الغدة الدرقية والجار الدرقية

الغدة البنكرياسية

الغدة الصنوبرية

مواضيع عامة في علم وظائف الاعضاء

الخلية الحيوانية

الجهاز العصبي

أعضاء الحس

الجهاز العضلي

السوائل الجسمية

الجهاز الدوري والليمف

الجهاز التنفسي

الجهاز الهضمي

الجهاز البولي


المضادات الميكروبية

مواضيع عامة في المضادات الميكروبية

مضادات البكتيريا

مضادات الفطريات

مضادات الطفيليات

مضادات الفايروسات

علم الخلية

الوراثة

الأحياء العامة

المناعة

التحليلات المرضية

الكيمياء الحيوية

مواضيع متنوعة أخرى

الانزيمات
الجنس Haemophilus influenzae
المؤلف:
عبد الرزاق سليمان التومي ، محمد محمد الامام ، عبد الباسط رمضان
المصدر:
اساسيات التشخيص البكتريولوجي المعملي والسريري
الجزء والصفحة:
19-7-2016
5570
Haemophilus influenzae
في عام 1892 عزل العالم Richard Pfeiffer هذا النوع البكتيري واطلق عليه اسم pfeiffer's bacillus وهو عبارة عن خلايا سالبة لصبغة جرام صغيرة الحجم حوالي 1.5 – 1.0 ميكرومتر طولاً و 0.3 ميكرومتر عرضاً . وغالباً ما يكون مكوناً للحافظة وغير متحرك وتصنف السلالات المكونة للحافظة إلى ستة أنواع مصلية (serovars a-f) بناءاً على السكريات المتعددة المكونة للحافظة ، ويعتبر النوع المصلي b المسئول على الإصابات التي تحدث في البشر.

صبغة جرام لعينة سائل النخاع الشوكي توضح الخلايا البكتيرية المحاطة بالحافظة.
الامراضية :
في الدول النامية فإن الإصابات الغازية الناتجة من النوع البكتيري Haemophilus influenza type b تعتبر المسبب الرئيسي لموت المواليد والأطفال، وهذه الإصابات غالباً ما تكون نتيجة تعفن الدم bactaeremic :
ــ التهاب السحايا الصديدي pyogenic (purulent) meningitis في الأطفال تحت سن 5 سنوات ومن النادر للأنواع المصلية a و e و f إحداث مرض التهاب السحايا.
ــ الإلتهاب الرئوي والتقيح pneumonia & empyema خاصة في الأشخاص البالغين.
ــ التهاب لسان المزمار الحاد acute epiglottitis مما قد يؤدي لإنسداد مجرى التهوية مسبباً الوفاة.
ــ التهاب النسيج الخلوي cellulitis والتهاب المفاصل sebtic arthritis والعديد من الإصابات الغازية الأخرى.
أما سلالات الانواع البكتيرية غير المصنفة مصلياً للجنس البكتيري H. influenza فهي في الغالب المسببة لألتهاب القصبات الهوائية المزمن chronic bronchitis والذي يصيب الأشخاص البالغين بصورة خاصة وكذلك إلتهابات الأذن الوسطى middle ear infections والتهاب الجيوب الأنفية paranasal sinusitis وإلتهاب ملتحمة العين conjuncitivitis . وهذه السلالات تشكل الفلورا الطبيعية للجهاز التنفسي العلوي في حوالي 70-50 % من البشر، بينما يتراوح نسبة الأشخاص الحاملين للنوع المصلي b حوالي 4-2% فقط.
التشخيص المعملي :
تعتبر زراعة عينة سائل النخاع الشوكي csf أو الصديد أو الدم أو عينة البلعوم الأنفي من أهم العينات التي يتم بها تشخيص الحالات المرضية، وهذه العينات يجب نقلها للمعمل بأسرع ما يمكن بعد تجميعها مع الحرص على عدم وضع العينات في الثلاجة.
يتطلب نمو المستعمرات البكتيرية وجود بيئة غنية بغاز ثاني أكسيد الكربون الرطب، ويمكن لهذه المستعمرات البكتيرية النمو في درجة الحرارة 40-20 درجة مئوية وتعتبر درجة الحرارة 37-35 درجة مئوية الدرجة المثلة للنمو ، كما يجب إحتواء الوسط الغذائي المستعمل على haemin أو porphtyrin المحتوي على الحديد وهو الذي يوفر عامر النمو X و nicotinamide adenine dinucleotide (NAD) و phosphate (NADP) وهم يوفران عامل النمو V . حيث إن عامل النمو X يحتاجه النوع البكتيري H. infeluenzae لإنتاج إنزيمات التنفس مثل cytochromes و catalase وإنزيم peroxidase بينما عامل النمو V يستعمل كحامل الإلكترونات في منظومة الأكسدة والاختزال.
ــ الوسط الغذائي chocolate agar : يحتوي هذا الوسط الغذائي على عاملي النمو X و V المتكون من تسخين الدم عند درجة حرارة 75 درجة مئوية لتجهيز هذا الوسط الغذائي بحيث يتم تثبيط إنزيم NADase المتوجد في المصل ويطلق عامل النمو V من كريات الدم الحمراء. بعد تحضين المزرعة البكتيرية في درجة حرارة 37-35 درجة مئوية مع توفير بيئة مشبعة بغاز ثاني أكسيد الكربون الرطب فإن المستعمرات البكتيرية النامية ستظهر على هيئة لزجة بقطر 1.5 مم أو اكبر. كما تتميز المزرعة البكتيرية برائحة مميزة وعند التعامل مع عينة البصاق فإنه يتم إضافة المضاد الحيوي bacitracin بتركيز 300 مج/لتر لجعل الوسط الغذائي انتقائي لعزل للنوع البكتيري H. influenza ومن غير الضروري إضافة هذا المضاد الحيوي عند التعامل مع عينة سائل النخاع الشوكي .
مستعمرات النوع البكتيري H. influenza على الوسط الغذائي chocolate agar
ـــ الوسط الغذائي blood agar : مستعمرات النوع البكتيري H. influenza تظهر صغيرة جداً في الحجم على الوسط الغذائي المجهز بإستعمال دم الحصان أو الأرنب، وقد تظهر إحلال كامل لكريات الدم من النوع بيتا. بينما لا يمكن لمستعمرات هذا النوع البكتيري النمو على الوسط المجهز بإستعمال دم الخراف.

طبق التعريف الرباعي Quad ID plate وهو يحتوي في الربع الأول (أعلى اليسار) عامل النمو X والربع الثاني (أعلى اليمين) يحتوي على النمو X&V، بينما الربع الثالث (أسفل اليمين) فهو يحتوي على heart infusion agar مضاف إليه 5% ثم حصان، والربع الرابع (أسفل اليسار) فهو يحتوي على عامل النمو V فقط.
يفرز النوع البكتيري S. aureus عامل النمو V ، فعند تنميته على الوسط الغذائي blood agar مع النوع البكتيري H. influenza فإن ذلك سيساعد على نمو هذا النوع البكتيري نتيجة توفر عامل النمو V ومركب haemin المنتج من إحلال كريات الدم الحمراء الذي يقوم به النوع البكتيري S. aureua وهذا ما يعرف باختبار satellitism test وهو اختبار بسيط لتحديد وجود النوع البكتيري H. influenza كما يمكن للجنس البكتيري S. pneumonia انتاج عامل النمو V الذي يساعد أيضاً على نمو النوع البكتيري H. influenza بخاصة satellitisn.
قبل بداية علاج الحالات المصابة بهذا النوع البكتيري يتم اختبار مدى إنتاج البكتيريا الممرضة إنزيم B- lactamase ، حيث أن السلالات المقاومة للمضادة الحيوي ampicillin منتشرة بصورة كبيرة في أغلب دول العالم، ويتواجد الجبن المسئول على هذه المقاومة على البلازميد plasmid mediated . كما أن هذا النوع البكتيري أظهر مقاومة المضاد الحيوي chloramphenicol ومع هذا فهناك عدد كبير من المضادات الحيوي التي يمكن استعمالها في العلاج. وللوقاية من الإصابة المرضية للأطفال يتم التحصين vaccination ضد هذا النوع البكتيري.

اختبار satellitism test
الاختبارات المعملية :
لايتم الاعتماد على هذه الاختبارات روتينياً للتفريق بين الأنواع المختلفة من هذا النوع البكتيري ، هناك 6 أنواع حيوية biotypes مختلفة بناءاً على إنتاج إنزيم urease وتكن الإندول indole وإنتاج إنزيم ornithine decarboxylase (ODC) 90% من سلالات النوع b تتبع النوع الحيوي biotype 1.
الاختبارات المصلية :
ــ الكشف على مستضد النوع البكتيري eH. influenza في عينة النخاع الشوكي : من الممكن استعمال الكواشف التجارية لإجراء الاختبارات السريعة للكشف على التفاعل المناعي التي تعتمد على مستضد السكريات المتعددة لحافظة النوع البكتيري H. influenzae b في عينة سائل النخاع الشوكي CSF. وهذا الاختبار سريع وسهل التطبيق كما أنه حساس ومحدد specific & sensitive اختبار بسيط للتأكد من تعريف النوع البكتيري H. infleunzaeبناء على الحاجة لعاملي النمو X و V
الاكثر قراءة في البكتيريا
اخر الاخبار
اخبار العتبة العباسية المقدسة
الآخبار الصحية

قسم الشؤون الفكرية يصدر كتاباً يوثق تاريخ السدانة في العتبة العباسية المقدسة
"المهمة".. إصدار قصصي يوثّق القصص الفائزة في مسابقة فتوى الدفاع المقدسة للقصة القصيرة
(نوافذ).. إصدار أدبي يوثق القصص الفائزة في مسابقة الإمام العسكري (عليه السلام)